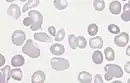

Anisopoikilocytosis
Anisopoikilocytosis is a medical condition illustrated by a variance in size (anisocytosis) and shape (poikilocytosis) of a red blood cell. The underlying cause can be attributed to various anemias, most often; beta thalassemia major, a form of microcytic anemia.[1] In β thalassemia major the beta hemoglobin chain is completely absent, rendering an increase in fetal hemoglobin (HbF).[2]
| Anisopoikilocytosis | |
|---|---|
![]() | |
| Slight to moderate anisopoikilocytosis in a case of polycythemia vera | |
| Specialty | Hematology |
References
- Alam, Kiran; Aziz, Mehar; Varshney, Manoranjan; Maheshwari, Veena; Basha, Mahfooz; Gaur, Kavita (2011-04-20). "Congenital dyserythropoietic anaemia type II: a rare entity". BMJ Case Reports. 2011: bcr0120113684. doi:10.1136/bcr.01.2011.3684. ISSN 1757-790X. PMC 3082060. PMID 22696622.
- Galanello, Renzo; Origa, Raffaella (2010-05-21). "Beta-thalassemia". Orphanet Journal of Rare Diseases. 5: 11. doi:10.1186/1750-1172-5-11. ISSN 1750-1172. PMC 2893117. PMID 20492708.
This article is issued from Wikipedia. The text is licensed under Creative Commons - Attribution - Sharealike. Additional terms may apply for the media files.